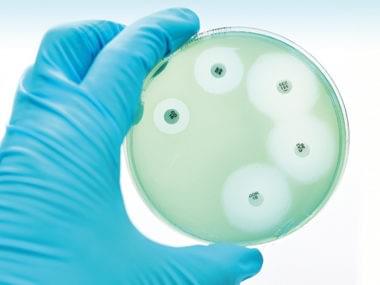
Section image

Wellspring Consulting Ltd
Expert support for charities (especially Learned Societies and Royal Charter charities)
I can take most of your governance worries from you, and I have a pragmatic and calm approach to compliance.
About Me
Who I am and how I can help

Who
Lucy Devine (used to be Carter), Director, Wellspring Consulting
I am a highly experienced governance adviser. I have more than 20 years’ experience of governance and change management delivery. I have supported governments of the UK, Africa, the UAE and Afghanistan, and held senior roles in a national and international NGO and a global consultancy firm. I now specialise in UK charities (particularly Learned Societies and Medical Colleges) and Multi-Academy Trusts. I have wide experience of all relevant roles, having been both a CEO and a Trustee for different charities, as well as providing external support.
I am also a fully qualified Chartered Governance Professional, and a Fellow of the Institute of Governance. I was awarded a Distinction for the Company Law paper in the Institute of Governance exams, and the AW Goodbody prize for the best financial decision-making paper in the June 2016 exam cohort. I hold the ICSA "Charity Law and Governance" certificate.Until recently, I was the external examiner for the NGA School Clerking qualification, and I was the tutor for the Institute of Governance "Academy Governance" qualification for three years.
Finally, I am a PRINCE2 practitioner.
How I can help
Our services
I can make your organisation's governance actually help you do what you need to do, rather than be a cumbersome extra layer of extra work.
I can also tick the boxes for you, and keep your regulator off your back.
And I work with a group of trusted and highly skilled associates to support all your "enabling" functions. - between us, we cover HR, strategic IT, finance, communications (including digital) and coaching. I can always recommend someone to help you.
Who I have worked with already
Previous and current clients
The Royal College of Physicians of Edinburgh
The Royal College of Ophthalmologists
The Royal College of Anaesthetists
The Royal Astronomical Society
The Royal Osteoporosis Society
The British Ecological Society
The Society for Applied Microbiology
The British Pharmacological Society
The Physiological Society
The Society for Endocrinology
The Genetics Society
The Royal Entomological Society
The International Union of Basic and Clinical Pharmacology
The Federation of European Microbiology Societies
The Society for Experimental Biology
mySociety
Sense about Science
BRACE
Help for charities
I advise charities; I've been a charity CEO, and I was a Trustee of Vision Aid Overseas (now Vision Action) for six years.
(NB all these photos are from when I worked in Africa, as there is no such thing as an interesting photo of governance in the UK!)

Governance review and support
Helping you work better
- A full Governance review, conducted with sympathy and pragmatism
- Providing training and/or coaching for all those involved in governance so that they understand their responsibilities and liabilities as Directors and Trustees
- Updating Articles of Association, from focus group to AGM
- A special focus for me is Learned Societies and Medical Colleges. I understand the particular challenges facing you, including:
- Moving from an amateur organisation to one run by professional staff
- Scientific hierarchies making robust challenge between Trustees difficult
- The tension between clinician involvement and staff roles
- Out-of-date Articles which are not clear about various Honorary Office roles
- Legacy Committees which may need to become Task and Finish groups
- Non-diverse Boards and Member voter apathy
- The risk to journal income from open access publishing

Technical support
Ticking the boxes for you
- Support for the governance elements of audit and preparation of annual financial statements
- Managing FOIA requests, new GDPR requirements
- Managing declarations of interest and any conflicts of interest
- Managing disclosure and transparency in line with requirements the Charity Commission and the Companies Act 2006 - ensuring that all the right information is on your websites
- Keeping company statutory records up to date
- Updating your Articles of Association if necessary
- Company secretary function, including all Companies House required returns, updates of appointments and resignations, and Persons of Significant Control declarations
- Ensuring that Trustees are aware of all regulatory requirements, Company and Charity law

Board support
Supporting Trustees
- Recruiting and induction of new Trustees and Members
- Board review and skills audit
- Creating and following a year Board calendar
Supporting Board and Committee meetings: drawing up the agenda, commissioning papers, quality assuring papers, circulating papers, attending meetings and taking minutes, and resolving any queries to do with the meeting.

Risk management
Sensible, realistic risk management
- Helping you make your risk management proportionate to your organisation, and being realistic about what you can really predict
- Refreshing and updating your risks: asking the right questions about mitigation and responsibility
- Creating an online risk register that enables quick and easy analysis by workstream, person, impact, overall score, "Board-level risk", last updated etc. This works on all devices including smartphones - it also lets staff add risks when they are not yet sure about the probability and impact assessment, but want to alert you to a potential problem
- Coaching staff on how to think about risk in a way that actually helps your charity, rather than getting the risk register out of cold storage once or twice a year
- Refreshing Trustees' understanding of their responsibility
Help for MATs and ATs
From full Governance review to dealing with Companies House
Board support
Making your Board run smoothly
- Recruiting and induction of new Trustees and Members
- Preparing Trustees and governors for Ofsted
- Board review and skills audit, based on DfE and ESFA guidance
- Creating and following a year Board calendar
- Writing the first draft of the Trustees' Annual Report
- Managing the AGM
- Advising on the difference between the Trustee role and the Member role
Supporting Board and Committee meetings: drawing up the agenda, commissioning papers, quality assuring papers, circulating papers, attending meetings and taking Ofsted-ready minutes, and resolving any queries to do with the meeting.
Wider governance
Making the Trust run smoothly
- A full Governance review, conducted with sympathy and pragmatism
- Providing training and/or coaching for all those involved in governance so that they understand their responsibilities and liabilities as Directors and Trustees, Members and local Governors
- Clarifying roles and responsibilities across the Trust, including drafting and implementing Schemes of Governance, Schemes of Delegation and Codes of Conduct
Technical governance
The dry bits
- Risk management: identifying and describing risks and mitigation activities so that you can easily check progress
- Support for audit and preparation of annual financial statements (writing the Statement of Governance, providing details of Trustees and Members)
- Managing FOIA requests, new GDPR requirements, and providing summarised Board meeting minutes for governors
- Managing declarations of interest and any conflicts of interest
- Managing disclosure and transparency in line with requirements of Articles, Academies Handbook and the Companies Act 2006 - ensuring that all the right information is on your websites
- Keeping company statutory records up to date
- Updating your Articles of Association if necessary, dealing with ESFA, Companies House and liaising with Members to agree the changes
- Company secretary function, including all Companies House required returns, updates of appointments and resignations, and Persons of Significant Control declarations
- Ensuring that Trustees are aware of all regulatory requirements, Company and Charity law, and DfE/ESFA/RSC/Ofsted guidance\
- Working with your Finance Director or Bursar to ensure that every requirement of the Academies Financial Handbook is covered
Local governance
Ensuring stakeholders are a real part of governance
- Developing communication channels between the Board and local governors
- Recruiting and inducting governors
- Arranging and supporting governors' meetings
- Facilitating cross-Trust governor groups
- Setting up PTAs and registering them as charities
- Setting up Parent Forums and Parent Voice groups
- Running parent surveys and "Listening surgeries"
- Managing Parent Governor elections
- Developing Terms of Reference for all parent representatives, to ensure clarity of roles
Lucy's Experience
Roles and projects
How It Works
Supportive, friendly governance
1Get in touch with me
Give me a few details about what kind of help you need - or tell me that you know you need some help but you don't know what!
Call, email, or fill out our form - see details below.
2Discuss your needs
Let's talk - I will come to meet you and you can tell me more
3Choose what feels right
I will summarise how I think I can help, and give you some options to choose from. You can go for none, some or all. There's no pressure.
Contact Me
You can ask me for any governance help or advice
Testimonials

Governance and risk management review for a Learned Society
From the CEO
Lucy’s expertise and experience was invaluable in our review of governance and risk management. Her outside perspective and knowledge of a wide range of other organisations helped us quickly identify areas for improvement and practical solutions. Her open and friendly style rapidly gained the trust and respect of everyone she worked with and I wouldn’t hesitate to recommend her services to organisations wanting to improve their governance.

Supporting Multi-Academy Trusts
From Board members
"I have had the pleasure of working with Lucy in her position as governance adviser on a non-profit board on which I serve as a trustee. Lucy is without exception one of the most the efficient, effective and charming people I have worked with in this and similar functions."
"The last year has seen significant progress in the effectiveness of the Board. Improvements to the quality of board papers, as well as the fact that papers are shared well in advance of meetings, has resulted in richer and more meaningful discussions of the trust's strategy, plans and progress"
"I first met Lucy as a director of a MAT for which she was a consultant. I was impressed with her ability to make the technical aspects of MAT Governance clearly understandable to all of us involved with the Academy’s schools. I was struck by her attention to detail and her ability to make what could be considered to some, quite complicated issues , clearly understandable to us so that we have been able to conduct the Academy’s business efficiently."

Supporting the Rwandan civil service with programme management and governance
Director of International Development for Save the Children UK
I worked alongside Lucy in Rwanda as part of Tony Blair's Africa Governance Initiative, where we provided strategic advice to the President and Prime Minister and capacity building support to their senior officials. Lucy was highly professional and widely respected for both her technical expertise and her personable approach to working alongside national staff. Her ability to adapt her advice according to her audience was particularly evident; she was as effective providing strategic advice to the President and his ministers as she was building the skills and confidence of lower capacity civil servants. Lucy's dedication and diligence, combined with her astute understanding of governance constraints, resulted in real progress in a short space of time, which in turn built the trust and confidence of our counterparts.

Senior Adviser to the Senior Minister of the Afghan government, contracted to DfID
From the consultant liaison lead
Overall I found Lucy to be a very hard-working, committed and reliable colleague who threw herself into a job in very tough working conditions and with some very trying adversaries/colleagues in Afghan government. The job routinely required 12 plus hour days and we work six days a week here and have relatively little freedom of movement, so anyone who can deliver good work in this kind of place is pretty resilient and able. The job chiefly involved coordinating with lots of other people in the international community, different ministries and agencies to ensure that the policies for various different governance sectors (eg public financial management, local government, anti-corruption, justice) were delivered in good shape and on time.
She was good fun to work with, intelligent and driven.

Working with the UK government on a project to reduce re-offending
From the consultant liaison lead
Lucy Carter (NB this was my old name - I got married recently!) has previously worked with us over several years on a number of separate, yet related projects intended to set out the complex accountabilities and relationships of the three lead Government departments and their relevant agencies involved in the delivery of learning and skills provision for offenders.
We appreciated and valued Lucy’s work. She helped to establish and instil a sense of collaborative working across a number of organisations, whose priorities were often competing and sometimes contradictory, at a time when this was missing. We found Lucy to be a most effective, reliable and amiable consultant; to us, she felt more part of the team than someone simply fulfilling a contract.

Governance Review for a Learned Society
From the CEO
Lucy has lead a Governance Review for the Society, looking at our decision-making processes, committee structure and behaviours during governance meetings. Her style is incredibly energetic and enthusiastic such that she’s made governance absolutely fascinating! The Executive Committee of trustees have taken on board all her recommendations and now we have a truly engaged group of trustees who all contribute significantly in our meetings which focus much more on strategic and governance-level discussion points and decisions. Even when critical, Lucy delivers her results in a positive and supportive way. I’d recommend Lucy’s expertise to anyone considering an independent assessment of their governance structures and processes.
© 2017